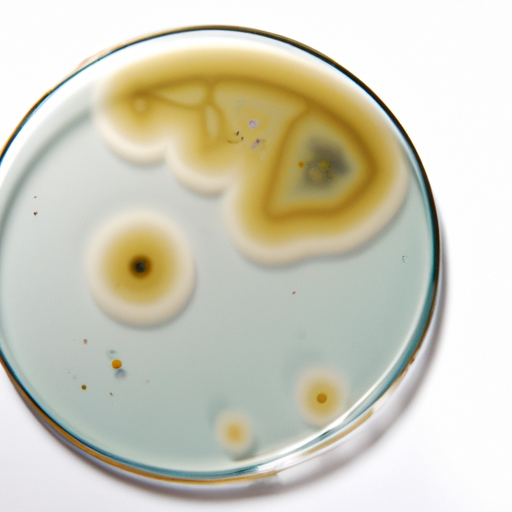

¿Puedo comer Agar caducado?
✅Aspecto Normal: Agar

⚠️Signos de Deterioro: Agar
🎥Ver: Guía de almacenamiento de Agar
Aprende consejos expertos para almacenar agar de forma segura y extender su vida útil.
Guía de Almacenamiento
Vida Útil
Signos de Deterioro
Crecimiento de moho, olor desagradable
Información Adicional
Usos alternativos: Sustituto de gelatina vegetariana, espesante para sopas, postres, agente clarificante en la elaboración de cerveza
Preguntas Frecuentes
¿Cuál es la diferencia entre la fecha de caducidad y la fecha de consumo preferente para Agar?
1. Fecha de caducidad: Indica cuándo un producto puede dejar de ser seguro para consumir. Fecha de mejor calidad: Sugiere cuándo un producto puede comenzar a perder su mejor calidad. 2. Los signos de degradación de calidad pueden incluir cambios de color o alteraciones de textura. Los signos de estropeo real incluyen el crecimiento de moho u olores desagradables. 3. El Agar generalmente mantiene su mejor calidad durante aproximadamente 2-3 años si se almacena adecuadamente. 4. El Agar puede volverse inseguro para consumir después de la fecha de caducidad si hay signos de estropeo o si se ha almacenado de manera incorrecta.
¿Cómo puedo saber si Agar se ha echado a perder?
Para determinar si el Agar se ha echado a perder, busca cualquier signo de decoloración, como un tinte amarillo o marrón. Además, un olor agrio o desagradable puede indicar estropeo. Verifica la textura del agar: si parece viscoso o pegajoso en lugar de firme y seco, es probable que ya no sea seguro para consumir.
¿Cuáles son los riesgos de seguridad alimentaria con Agar?
1. Las enfermedades transmitidas por alimentos comunes asociadas con el Agar: No hay enfermedades transmitidas por alimentos específicas asociadas con el Agar en sí, ya que es un tipo de agente espesante derivado de algas marinas. Sin embargo, la contaminación durante el procesamiento o la manipulación incorrecta después de la preparación puede provocar el crecimiento de bacterias y posibles enfermedades transmitidas por alimentos. 2. Grupos de alto riesgo que deben tener precaución adicional: Grupos de alto riesgo como mujeres embarazadas, niños pequeños, personas mayores y aquellos con sistemas inmunológicos debilitados deben tener precaución adicional al consumir platos preparados con Agar debido a su mayor susceptibilidad a enfermedades transmitidas por alimentos. 3. Advertencias críticas de seguridad: Es crucial asegurarse de que el Agar se obtenga, almacene y prepare correctamente para evitar la contaminación. Evita consumir platos que contengan Agar que se hayan dejado a temperatura ambiente durante un período prolongado o que no se hayan almacenado adecuadamente. 4. Prácticas seguras de manipulación: Al preparar platos con Agar, asegúrate de seguir las prácticas adecuadas de seguridad alimentaria, como lavarse las manos antes y después de manipularlo, usar utensilios y equipos limpios y almacenar los sobrantes rápidamente en el refrigerador. Además, asegúrate de obtener el Agar de proveedores confiables y almacenarlo en un lugar fresco, seco y alejado de la humedad y los contaminantes.
¿Cuáles son los mejores consejos para almacenar Agar?
1. Mejores prácticas de almacenamiento para el Agar: Almacena en un recipiente hermético en un lugar fresco y seco, alejado de la humedad y la luz solar directa. 2. Soluciones creativas de almacenamiento: Utiliza frascos de vidrio herméticos o bolsas resellables para mantener el Agar fresco y evitar que se aglomere. 3. Consejos para prolongar la vida útil: Mantén el Agar alejado de olores fuertes, ya que puede absorberlos, y utiliza un absorbedor de humedad en el recipiente de almacenamiento para evitar que se aglomere. 4. Errores comunes de almacenamiento que debes evitar: Evita almacenar el Agar en un ambiente húmedo o cerca de fuentes de calor, ya que esto puede acortar su vida útil y calidad.
¿Hay datos interesantes sobre Agar?
1. El Agar, también conocido como agar-agar, es una sustancia gelatinosa derivada de algas marinas. Se ha utilizado en la preparación de alimentos durante siglos y se originó en Japón en el siglo XVII. 2. El Agar se utiliza ampliamente en las cocinas asiáticas, especialmente en Japón, China y el sudeste asiático. Es un ingrediente esencial en la elaboración de postres tradicionales japoneses como el yokan y el anmitsu. En China, se utiliza en sopas dulces y platos de gelatina. En el sudeste asiático, se utiliza en postres como la gelatina de agar-agar. 3. El Agar es apto para vegetarianos y veganos, lo que lo convierte en una alternativa popular a la gelatina, que se obtiene de fuentes animales. El Agar también es conocido por su alto contenido de fibra y a menudo se utiliza como suplemento dietético por sus posibles beneficios para la salud. 4. Tradicionalmente, el Agar se ha utilizado no solo en la cocina, sino también en microbiología como medio de cultivo para el crecimiento de bacterias y otros microorganismos. También se utiliza en la producción de cosméticos, productos farmacéuticos e incluso en investigaciones científicas por sus propiedades únicas como agente solidificante.
Calculadora de Caducidad
Fuentes
Para más información sobre seguridad alimentaria y pautas de caducidad, visita nuestra página de Fuentes.
Escanea tu alimento directamente y obtén información de seguridad al instante usando nuestra función de cámara con IA.
Alimentos Relacionados
Más de
Caldo o Sopa de Pescado Casero
Ver guía de almacenamiento →
Tahini
Ver guía de almacenamiento →
Ajo Picado
Ver guía de almacenamiento →
Aceite de Coco
Ver guía de almacenamiento →
Aceite de Oliva
Ver guía de almacenamiento →
Aceite de sésamo
Ver guía de almacenamiento →
Comino Molido
Ver guía de almacenamiento →
Grasa de Pato Goteos Casera
Ver guía de almacenamiento →
Pasta de Jengibre Empaquetada Comercialmente Abierta
Ver guía de almacenamiento →
Requisitos de Almacenamiento Similares
Frutas Variadas Secas
Ver guía de almacenamiento →
Sopa de Nido de Pájaro
Ver guía de almacenamiento →
Chowder de Pescado enlatado o embotellado comercial sin abrir
Ver guía de almacenamiento →
Ostras ahumadas enlatadas comercialmente sin abrir
Ver guía de almacenamiento →
Gomitas Multivitamínicas
Ver guía de almacenamiento →
Polvo de Malta
Ver guía de almacenamiento →
Umeboshi Ciruelas Japonesas encurtidas
Ver guía de almacenamiento →
Frijol de vaca
Ver guía de almacenamiento →
Bardana
Ver guía de almacenamiento →
Revisado Por: Expertos en Seguridad Alimentaria y Caducidad
En ¿Puedo Comer Caducado?, nos comprometemos a proporcionar información precisa y basada en la ciencia sobre la caducidad y seguridad del almacenamiento de alimentos. Nuestro contenido es cuidadosamente revisado según las pautas de las principales organizaciones de seguridad alimentaria, incluyendo:
- ✅Administración de Alimentos y Medicamentos (FDA) – Guías de Seguridad Alimentaria
- ✅Departamento de Agricultura de EE. UU. (USDA) – Almacenamiento y Fechas de Caducidad
- ✅Organización Mundial de la Salud (OMS) – Enfermedades Transmitidas por Alimentos y Seguridad
- ✅Centros para el Control y la Prevención de Enfermedades (CDC) – Prevención de Enfermedades Transmitidas por Alimentos
🔍 Cómo Aseguramos la Precisión
- Utilizamos fuentes oficiales de seguridad alimentaria para guiar nuestras recomendaciones.
- Nuestro equipo revisa y actualiza continuamente el contenido según las últimas investigaciones.
- Alentamos a los usuarios a verificar siempre los signos de deterioro y seguir las pautas de almacenamiento adecuadas.
📚 ¿Tienes Preguntas?
Si tienes preocupaciones específicas sobre la caducidad o seguridad de los alimentos, te recomendamos consultar a un dietista registrado, científico de alimentos o tu departamento de salud local.